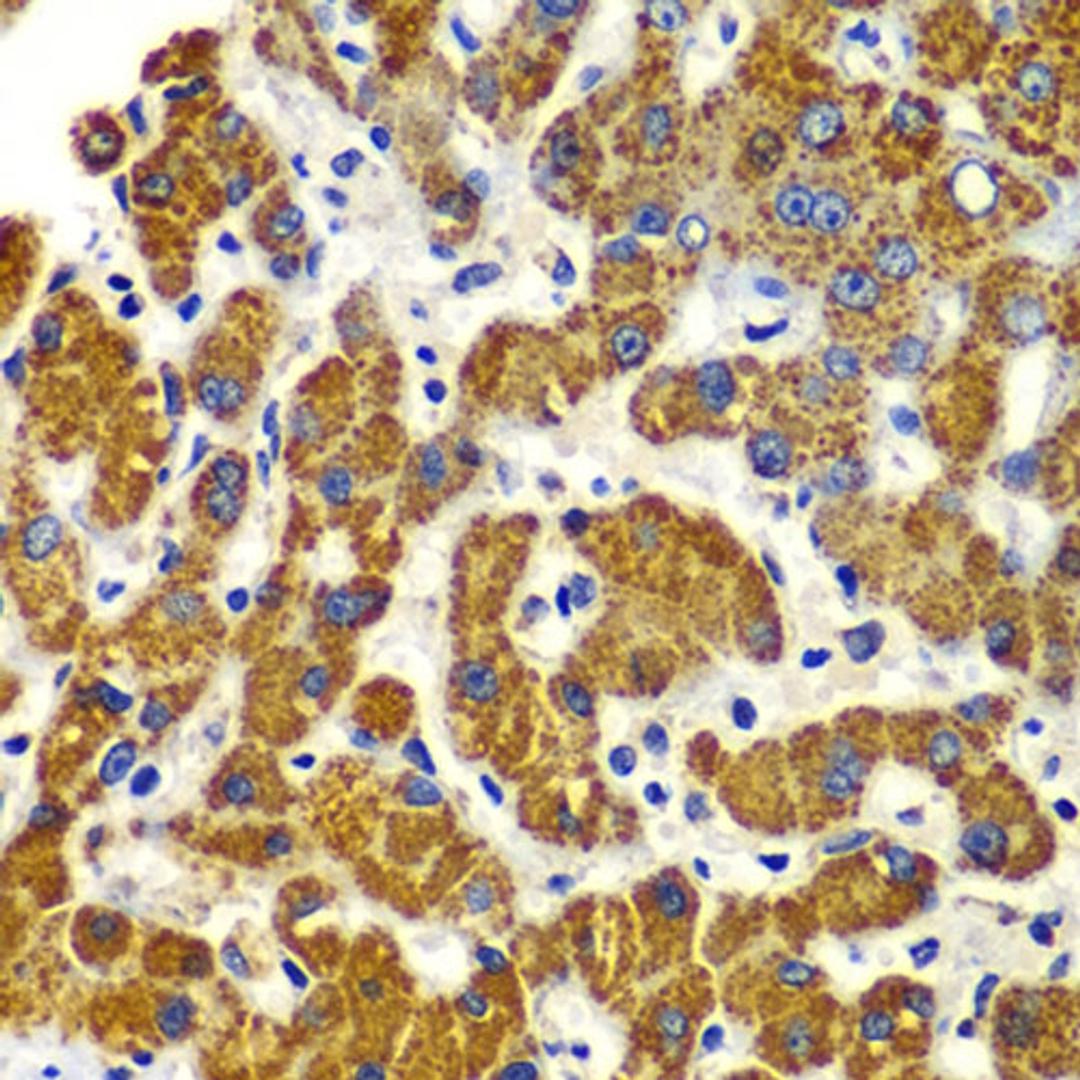
Immunohistochemistry - SMAD9 antibody (A7518)
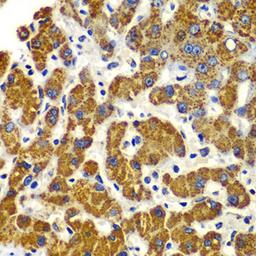
Immunohistochemistry - SMAD9 antibody (A7518)

Product & ReviewsAntibodies
SMAD9 Rabbit pAb
Product Details
- Cat. No.
- A7518
- Type
- Primary Antibody
- Clonality
- Polyclonal
- Host
- Rabbit

The supplier does not provide quotations for this antibody through SelectScience. You can search for similar antibodies in our Antibody Directory.
Description
The protein encoded by this gene is a member of the SMAD family, which transduces signals from TGF-beta family members. The encoded protein is activated by bone morphogenetic proteins and interacts with SMAD4. Two transcript variants encoding different isoforms have been found for this gene.
Biological Information
- Clonality: Polyclonal
- Host: Rabbit
- Reactivity: Human, Mouse, Rat